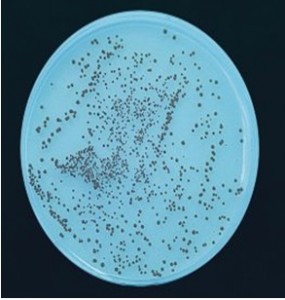
CANDIDA

CANDIDA ALBICANS BIGGY NICKERSON AGAR. Detección de Candida albicans por sus colonias color pardo (no crema, marrón o negro)
COMPOSICIÓN
- Extracto de levadura 1.0 g
- Glicina 10.0 g
- Glucosa 10.0 g
- Citrato-bismuto amoniacal 5.0 g
- Sulfito sódico 3.0 g
- Agar‑agar 15.0 g
(Fórmula por litro) pH final: 6,8 ± 0,2
PREPARACIÓN
Disolver 44 g de medio en 1 litro de agua estilada. Calentar hasta ebullición, agitando ara su disolución. Mantener la ebullición durante un máximo de 2 minutos.
NO autoclavar ni sobrecalentar o el medio virará a gris.
Medio que, una vez preparado, gana calidad con el tiempo, mientras se mantenga blanco (1-2 años).
PARA USO EXCLUSIVO EN LABORATORIO
MANTENGA EL BOTE BIEN CERRADO EN LUGAR SECO, FRESCO Y OSCURO. AGITE EL BOTE ANTES DE USAR.
DESHIDRATADO CODIGO: DMT017
PRESENTACIÓN: TUBOS INCLINADOS CON PICO LARGO, FRASCOS 100 ml, MEDIO DESHIDRATADO
CONTROL DE CALIDAD DEL MEDIO
Realizado en nuestro laboratorio; es prudente repetirlo en su laboratorio siempre que varíen las condiciones (más de 3 meses sin usar, tras desinfectar laboratorio, tras conservar a alta Tª, cuando adquiere aspectos extraños aunque no haya llegado la fecha de caducidad teórica de la etiqueta,…).
DESHIDRATADO: Polvo fino, Beige PREPARADO: Estéril, Blanco.
CONTROL DE CRECIMIENTO 48-72 h a 37°C aproximadamente, o bien a temperatura ambiente (aprox.21-28°C):
- Candida albicans MKTA 10231, Excelente, Colonia marrón sin difusión de pigmento al medio. Con respecto a PCA estandarizado*, recuento 114-119%, pero de forma selectiva.
- Candida tropicalis MKTA 1005, Excelente, Colonia con difusión del color negro-metálico al medio. Con respecto a PCA estandarizado*, recuento 115%, pero de forma selectiva.
- Escherichia coli MKTA 25922, Inhibido.
- Staphylococcus aureus MKTA 6538P, Inhibido.
* El que cumple con recuperación superior al 92-125% con respecto a cepas cuantitativas trazables a la cepa tipo. Incertidumbres detectadas entre todos los lotes a lo largo de un año (la mayoría de la incertidumbre se debe a la cepa y a la proporción de cepas acompañantes inoculadas, no al medio).
NOTA:
Bismuto‑Sulfito‑Glucosa‑Glicina‑Yeast Agar (BIGGY) es un medio selectivo para Candida. El sulfito de Bismuto inhibe la flora bacteriana y es reducido a pardo oscuro por las Candida. El medio es tan bueno Para C.albicans que no ha sido mejorado por los medios cromogénicos.
SIEMBRA
Fundir frascos a 98 ºC para elaborar placas sin sobrecalentar. Sembrar en superficie, exclusivamente con asa de Platino (VCS147). A pesar de ser una levadura, si se siembra en masa, se obtendrán recuperaciones incluso 3 veces inferiores y colonias más tardías y diminutas.
Incubar durante 1‑3 días a 35 ºC aproximadamente.
Izda: siembra en superficie; Dcha: siembra en masa, mucho menos eficiente para este microorganismo
INTERPRETACIÓN
Candida albicans forma colonias negras o pardo oscuras, sin brillo metálico ni difusión de pigmentos al medio. Candida tropicalis: colonias pardo‑oscuras con centro negro, con reflejo metálico y con pigmento negro que difunde alrededor de las colonias tras 72 horas. C. pseudotropicalis: colonias pardo‑rojizas oscuras, brillantes, sin difusión. Candida krusei: colonias rugosas, plateadas‑pardo‑negruzcas, con halo de difusión amarillo. C. parakrusei: colonias rugosas, pardo‑rojizas, con micelio amarillo alrededor. Candida stellatoidea: colonias pardo‑oscuras con leve reborde micelial.
Si desea más información sobre nuestros MEDIO BIGGY NICKERSON CANDIDA AGAR, rellene nuestro formulario de contacto http://www.medioscultivo.com/contacto . O si lo prefiere póngase en contacto con nosotros a través de nuestro correo electrónico microkit@microkit.es o por teléfono en el nº 91-897 46 16
https://www.microkit.es/fichas/BIGGY-NICKERSON-CANDIDA-AGAR.pdf

muy excelente medio de identificación me gustaría conocer mas información y costo del medio para Bolivia Santa cruz
Buenos días
Respondemos a su consulta desde nuestro correo general.
Muchas gracias por visitar nuestro blog y contactar con nosotros. Un cordial saludo